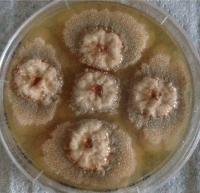
Picture2

The genetic recipe book for natural medicinal compounds

Professor Emily Parker FRSNZ from Victoria University of Wellington will investigate how subtle genetic differences create diverse and useful chemical compounds in fungi. The results will help us tailor-make compounds with medicinal uses.
Published 8 November 2018
One of their indole diterpene producer fungi, Hypoxylon ulicicidum (Photo: Kyle van de Bitter)
Living organisms make a diverse suite of natural chemicals, allowing them to combat predators, fight off pathogens and meet specific environmental challenges. These compounds have been the leading source of medications for millennia. Our ancestors chewed certain herbs to relieve pain or wrapped leaves around wounds to improve healing. Today, these natural products are the richest source of compounds in modern drug discovery and development.
Professor Emily Parker from the Ferrier Research Institute at Victoria University of Wellington has received a Marsden Fund grant to investigate a family of bioactive compounds found in fungi known as indole diterpenes. This family of compounds has important anti-viral, anti-bacterial and anti-cancer properties, as well as acting as a natural insecticide. In previous work, Professor Parker was part of the team that discovered the genes responsible for the creation of indole diterpenes. In this project, she will examine small genetic variations that enable fungi to produce a diverse range of indole diterpene compounds. These variations will provide a recipe book for producing different and potentially useful compounds.
This research will provide a better understanding of how different organisms develop their unique chemical signatures at a molecular level. The results will allow us to tailor-make compounds with enhanced and useful bioactive properties for medicinal use.
